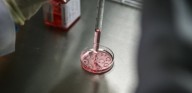
Cientistas inventam mais um método que possibilita escolher o sexo de bebês

O Poço Superprofundo de Kola e as vozes das almas condenadas ao Inferno (Parte 2)
21 de Setembro de 2019 Postado às 12:54
O Poço Superprofundo de Kola e as vozes das almas condenadas ao inferno (Parte 1)
21 de Setembro de 2019 Postado às 11:52
Cientistas inventam mais um método que possibilita escolher o sexo de bebês
02 de Setembro de 2019 Postado às 22:52
SUMMA DAEMONIACA - Tratado de Demonologia e Manual de Exorcistas
09 de Agosto de 2019 Postado às 16:07
Japão aprova primeiros experimentos com embriões de humanos e animais
09 de Agosto de 2019 Postado às 09:52
Mensagens de DEUS ao Apóstolo dos Tempos Finais - APTF
Alertas vindos do Céu
Mensagens de Jesus a John Leary (Em Inglês)
Mensagens ao Discípulo
Aparições Marianas
Vida dos Santos | Orações | Solenidades católicas
Cumprimento do Apocalipse
Satanismo no mundo | Abominações que atraem a ira de Deus
Sinais extraordinários/Estranhos acontecimentos
Sonhos | Visões | Profecias | Interessantes
Conhecendo o que nos escondem
Saúde do corpo, mente e espírito | Vida Natural